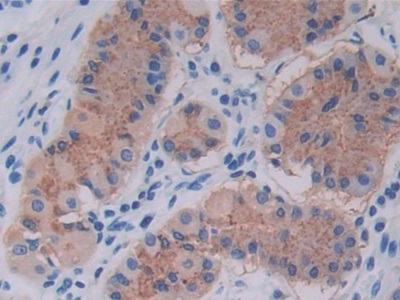

Monoclonal Antibody to Cross Linked C-Telopeptide Of Type I Collagen (CTXI) 

CTX-I; CTX1;
- UOM
- FOB US$ 170.00 US$ 396.00 US$ 565.00 US$ 1,413.00 US$ 5,650.00
- Quantity
Overview
Properties
- Product No.MAA665Mi23
- Organism SpeciesHomo sapiens (Human) Same name, Different species.
- ApplicationsIHC; ICC/IF
If the antibody is used in flow cytometry, please check FCM antibodies.
Research use only - DownloadInstruction Manual
- CategoryMetabolic pathwayBone metabolism
- SourceMonoclonal antibody preparation, Host Mouse
- Ig Isotype N/A, Clone Number C8
- PurificationProtein A + Protein G affinity chromatography
- LabelNone
- Immunogen n/a
- Buffer Formulation0.01M PBS, pH7.4, containing 0.05% Proclin-300, 50% glycerol.
- TraitsLiquid, Concentration 1mg/ml
Sign into your account
Share a new citation as an author
Upload your experimental result
Review

Contact us
Please fill in the blank.
Specifity
The antibody is a mouse monoclonal antibody raised against CTXI. It has been selected for its ability to recognize CTXI in immunohistochemical staining and western blotting.
Usage
Western blotting: 0.5-2µg/mL;
Immunohistochemistry: 5-20µg/mL;
Immunocytochemistry: 5-20µg/mL;
Optimal working dilutions must be determined by end user.
Storage
Store at 4°C for frequent use. Stored at -20°C in a manual defrost freezer for two year without detectable loss of activity. Avoid repeated freeze-thaw cycles.
Stability
The thermal stability is described by the loss rate. The loss rate was determined by accelerated thermal degradation test, that is, incubate the protein at 37°C for 48h, and no obvious degradation and precipitation were observed. The loss rate is less than 5% within the expiration date under appropriate storage condition.
Organism Species More: Homo sapiens (Human)Giveaways
Increment services
Citations
- Atp6v0d2 Is an Essential Component of the Osteoclast-Specific Proton Pump That Mediates Extracellular Acidification in Bone ResorptionPubMed: PMC2672205
- Borage and fish oils lifelong supplementation decreases inflammation and improves bone health in a murine model of senile osteoporosisPubMed: 21664309
- Is there benefit in optimising heart failure treatment in over-80 year-old patients? (HF-80 study): study protocol for a randomized controlled trial.Trials: 1745-6215
- TRAF family member-associated NF-κB activator (TANK) is a negative regulator of osteoclastogenesis and bone formationPubMed: 22773835
- A Mediterranean Diet Enriched with Olive Oil Is Associated with Higher Serum Total Osteocalcin Levels in Elderly Men at High Cardiovascular RiskPubMed: PMC3462931
- Oxytocin Reverses Ovariectomy-Induced Osteopenia and Body Fat GainEndocrine: Source
- DPP IV inhibitor treatment attenuates bone loss and improves mechanical bone strength in male diabetic ratsPubmed:25053403
- Relation of burden of myocardial fibrosis to malignant ventricular arrhythmias and outcomes in Fabry diseasePubmed:25073565
- Bone resorption correlates with the frequency of CD5+ B cells in the blood of patients with rheumatoid arthritisPubmed:25193807
- XPO1/CRM1-Selective Inhibitors of Nuclear Export (SINE) reduce tumor spreading and improve overall survival in preclinical models of prostate cancer (PCa)Pubmed:25284315
- The presence of FCGR2B promoter or transmembrane region variant alleles leads to reduced serum IL-6 levels in rheumatoid arthritisPubmed:25630523
- 5-azacytidine-induced protein 2 (AZI2) regulates bone mass by fine-tuning osteoclast survivalPubmed:25691576
- Osteocartilaginous metabolic markers change over a 3-week stage race in pro-cyclistsPubMed: 26174975
- Effects of renal tubular dysfunction on bone in tenofovir-exposed HIV-positive patientsPubMed: 26372384
- Biomarkers in Remission According to Different Criteria in Patients with Rheumatoid ArthritisPubMed: 26472417
- Curcumin alleviates glucocorticoid-induced osteoporosis through the regulation of the Wnt signaling pathwayPubMed: 26677102
- Mutation in Osteoactivin Promotes RANKL-Mediated Osteoclast Differentiation and Survival, but Inhibits Osteoclast FunctionPubMed: 25837253
- Oxytocin reverses osteoporosis in a sex-dependent mannerPubMed: 26042090
- The RIP1–RIP3 Complex Mediates Osteocyte Necroptosis after Ovariectomy in Ratspmc:PMC4795547
- Lanthanum Chloride Attenuates Osteoclast Formation and Function Via the DownreCavia (Guinea pig )lation of Rankl-Induced Nf-κb and Nfatc1 ActivitiesPubmed:26060084
- N-Homocysteinylation impairs collagen cross-linking in cystathionine β-synthase-deficient mice: a novel mechanism of connective tissue abnormalities.pubmed:27530978
- High FGF21 levels are associated with altered bone homeostasis in HIV-1-infected patients.pubmed:28521869
- The effect of calcium and vitamin D supplementation on bone health of male Jockeys.pubmed:27568072
- Ginsenosides Rg3 attenuates glucocorticoid-induced osteoporosis through regulating BMP-2/BMPR1A/Runx2 signaling pathwaypubmed:27387537
- The effect of lamotrigine and phenytoin on bone turnover and bone strength: A prospective study in Wistar ratspubmed:27838501
- Reduced femoral bone mass in both diet-induced and genetic hyperlipidemia micepubmed:27669658
- A potential role for glycated cross-links in abdominal aortic aneurysm disease.pubmed:27624703
- Effects of long-term administration of pantoprazole on bone mineral density in young male rats.pubmed:27552060
- Anti-osteoporotic effects of an antidepressant tianeptine on ovariectomized ratsS0753332216322752
- Cannabidiol administration reduces sublesional cancellous bone loss in rats with severe spinal cord injurypubmed:28479140
- Side-Effects of Convulsive Seizures and Anti-Seizure Therapy on Bone in a Rat Model of Epilepsypubmed:28905646
- Obesity status influences the relationship among serum osteocalcin, iron stores and insulin sensitivitypubmed:29050649
- A novel osteoporosis model with ascorbic acid deficiency in Akr1A1 gene knockout mice.pubmed:28060768
- 骨形成指标PINP 与骨吸收指标β-CTX 在2 型糖尿病合并骨质疏松中作用的研究.10.3969/j.issn.1006-7108.2017.03.009
- Optimization of the Time Window of Interest in Ovariectomized Imprinting Control Region Mice for Antiosteoporosis Researchpubmed:29119115
- TSC1 regulates osteoclast podosome organization and bone resorption through mTORC1 and Rac1/Cdc42Pubmed:29358671
- The role of androgens on periodontal repair in female ratsPubmed:29683499
- Myricetin ameliorates glucocorticoid-induced osteoporosis through the ERK signaling pathwayPubmed:29883721
- The effect of levetiracetam on rat bone mineral density, bone structure and biochemical markers of bone metabolismPubmed:29428468
- Geometric and mechanical bone response to a multidisciplinary weight loss intervention in adolescents with obesity: The ADIBOX studyPubmed:30076009
- Effects of Amlodipine on Bone Metabolism in Orchidectomised Spontaneously Hypertensive RatsPubmed:29898457
- Liraglutide exerts a bone‑protective effect in ovariectomized rats with streptozotocin‑induced diabetes by inhibiting osteoclastogenesisPubmed:29805533
- Combination therapy with BMP‑2 and psoralen enhances fracture healing in ovariectomized mice10.3892:etm.2018.6353
- Dual PI3 K/mTOR inhibition reduces prostate cancer bone engraftment altering tumor-induced bone remodelingPubmed:29687745
- Membrane-Based Microwave-Mediated Electrochemical Immunoassay for the In Vitro, Highly Sensitive Detection of Osteoporosis-Related BiomarkersPubmed: 30181433
- Mollugin attenuates glucocorticoid-induced osteoporosis in rats via Akt/P13K pathway
- Transcriptome analysis of osteoblasts in an ovariectomized mouse model in response to physical exercise
- Influence of physical training on markers of bone turnover, mechanical properties, morphological alterations, density and mineral contents in the femur of rats exposed …Pubmed: 30983556
- Serum biomarkers for predicting overall survival and early mortality in older patients with metastatic solid tumorsPubmed: 30952517
- Significance of the Tks4 scaffold protein in bone tissue homeostasis
- E The Effects of Ficus Carica Fruit on Bone Markers and Oestrogen Level of Post-Menopausal Osteoporotic Rats
- Osteocyte TSC1 promotes sclerostin secretion to restrain osteogenesis in micePubmed: 31088250
- Role of testosterone and androgen receptor in periodontal disease progression in female ratsPubmed: 31389012
- Biomarkers of oral inflammation in perinatally HIV‐infected and perinatally HIV exposed, uninfected youthPubmed: 31385616
- Laboratory Monitoring of Bone Tissue Remodeling after Augmentation of Impression Intraarticular Fracture with Different Types of Bone GraftPubmed: 31630302
- AAV-anti-miR-214 prevents collapse of the femoral head in osteonecrosis by regulating osteoblast and osteoclast activitiesPubmed: 31739209
- Alleviating Effect of α-Lipoic Acid and Magnesium on Cadmium-Induced Inflammatory Processes, Oxidative Stress and Bone Metabolism Disorders in Wistar RatsPubmed: 31739465
- Differences in Osteoimmunological Biomarkers Predictive of Psoriatic Arthritis among a Large Italian Cohort of Psoriatic PatientsPubmed: 31717649
- Beneficial effects of Cuscuta chinensis extract on glucocorticoid-induced osteoporosis through modulation of RANKL/OPG signalsPubmed: 31826180
- BMP9 reduces bone loss in ovariectomized mice by dual regulation of bone remodelingPubmed: 31914211
- EDTA-Modified 17β-Estradiol-Laden Upconversion Nanocomposite for Bone-Targeted Hormone Replacement Therapy for OsteoporosisPubmed: 32194868
- Article Dual CXCR4 and E-Selectin Inhibitor, GMI-1359, Shows Anti-Bone Metastatic Effects and Synergizes with Docetaxel in Prostate Cancer Cell Intraosseous …Pubmed: 31877673
- RNA Sensing by Gut Piezo1 Is Essential for Systemic Serotonin SynthesisPubmed: 32640190
- A Loop‐Based and AGO‐Incorporated Virtual Screening Model Targeting AGO‐Mediated miRNA–mRNA Interactions for Drug Discovery to Rescue Bone Phenotype …Pubmed: 32670749
- The Effects of Ficus Carica Fruit on Bone Markers and Oestrogen Level of Post-Menopausal Osteoporotic Rats.
- Dual CXCR4 and E-Selectin Inhibitor, GMI-1359, Shows Anti-Bone Metastatic Effects and Synergizes with Docetaxel in Prostate Cancer Cell Intraosseous …
- Qu Feng Zhi Tong capsule increases mechanical properties of cortical bone in ovariectomized rats
- 4-Hexylresorcinol Inhibits Osteoclastogenesis by Suppressing NF‐κB Signaling Pathway and Reverses Bone Loss in Ovariectomized Mice
- The Effects of Ficus Carica Fruit on Bone Markers and Oestrogen Level of Post-Menopausal Osteoporotic Rats
- 淫羊藿水提物及提取药渣的抗骨质疏松药效比较研究
- Postmenapozal Tip-2 diyabetes mellitus' lu hastalarda osteoporoza bağlı kırık riskinin ve kemik Turnoveri'nin değerlendirilmesi
- A biomimetically hierarchical polyetherketoneketone scaffold for osteoporotic bone repair33310848
- Lgr4 promotes aerobic glycolysis and differentiation in osteoblasts via the canonical Wnt/¦Â©\catenin pathway33950533
- Andrographolide prevents bone loss via targeting ERRalpha‐regulated metabolic adaption of osteoclastogenesis34233019
- Effects of icariin on the fracture healing in young and old rats and its mechanism34511043
- Gujiansan Ameliorates Avascular Necrosis of the Femoral Head by Regulating Autophagy via the HIF-1α/BNIP3 Pathway34512780
- Dual integrin αvβ3 and αvβ5 blockade attenuates cardiac dysfunction by reducing fibrosis in a rat model of doxorubicin-induced cardiomyopathy34296634
- Night shift work and osteoporosis-bone turnover markers among female blue-collar workers in PolandPubmed:35139709
- Defects in a liver-bone axis contribute to hepatic osteodystrophy disease progressionPubmed:35235775
- BMP9 reduces age-related bone loss in mice by inhibiting osteoblast senescence through Smad1-Stat1-P21 axisPubmed:35523787
- Foxf2 represses bone formation via Wnt2b/β-catenin signalingPubmed:35668101
- Osteoporotic bone recovery by a bamboo-structured bioceramic with controlled release of hydroxyapatite nanoparticlesPubmed:35386445
- Puerarin specifically disrupts osteoclast activation via blocking integrin-β3 Pyk2/Src/Cbl signaling pathwayPubmed:35228997
- Exercised accelerated the production of muscle-derived kynurenic acid in skeletal muscle and alleviated the postmenopausal osteoporosis through the Gpr35 …